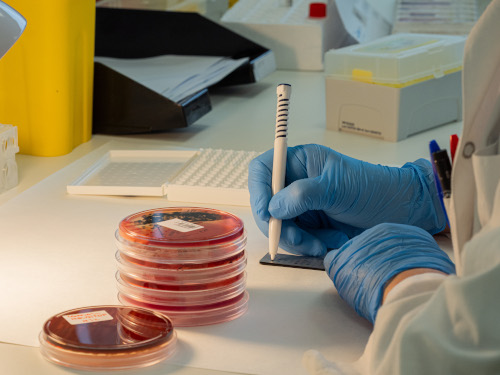

Laboratori Clínic
Un servei cabdal per al diagnòstic, tractament i prevenció
Què ens fa diferents?

Formació i coneixement

Innovació tecnològica

Qualitat (certificats norma ISO 9001)
Sobre el servei
El Laboratori Clínic del Consorci Hospitalari de Vic realitza anualment 2,5 milions de determinacions a partir de l’anàlisi quantitativa i qualitativa de mostres biològiques del cos humà.
Aquests estudis són essencials per al diagnòstic, pronòstic, tractament, seguiment i prevenció de malalties, donant suport a la presa de decisions mèdiques en tots els àmbits assistencials.
El laboratori atén les sol·licituds provinents dels centres del Consorci Hospitalari de Vic, de l’Atenció Primària, serveis sociosanitaris i mutuals, i ofereix servei 24 hores al dia, 365 dies a l’any, a tota la població d’Osona.
Comptem amb una àmplia cartera de serveis i proves d’alt valor diagnòstic, organitzats en diferents àrees de coneixement.

Tenim acreditada docència per a la formació d'especialistes en Anàlisis Clíniques des de l'any 2000.
Oferim activitat docent de pregrau per a Tècnics Especialistes de Laboratori.
Apostem per una formació continuada de qualitat, aspecte fonamental per donar una bona assistència.
Els nostres professionals del Laboratori participen en activitats d'investigació, inclosa la realització de tesis doctorals, publicacions científiques i presentacions a congressos, entre d’altres.
També participen diferents projectes i grups de treball relacionats amb les nostres sots especialitats del laboratori i amb empreses de diagnòstic de l’àrea en el desenvolupament de reactius de laboratori.

El servei està certificat amb la norma UNE-EN-ISO 9001:2015, que garanteix l’excel·lència en tots els processos.
Apliquem controls interns continus i participem en programes externs de qualitat de referència nacional i internacional, assegurant així la fiabilitat i la seguretat dels resultats.
Cada prova és realitzada amb la màxima precisió per professionals altament qualificats, combinant tecnologia avançada i protocols de qualitat estrictes. A continuació, es detallen les principals àrees de coneixement i serveis disponibles:

El Laboratori Clínic del Consorci Hospitalari de Vic realitza anualment 2,5 milions de determinacions a partir de l’anàlisi quantitativa i qualitativa de mostres biològiques del cos humà.
Aquests estudis són essencials per al diagnòstic, pronòstic, tractament, seguiment i prevenció de malalties, donant suport a la presa de decisions mèdiques en tots els àmbits assistencials.
El laboratori atén les sol·licituds provinents dels centres del Consorci Hospitalari de Vic, de l’Atenció Primària, serveis sociosanitaris i mutuals, i ofereix servei 24 hores al dia, 365 dies a l’any, a tota la població d’Osona.
Comptem amb una àmplia cartera de serveis i proves d’alt valor diagnòstic, organitzats en diferents àrees de coneixement.

Tenim acreditada docència per a la formació d'especialistes en Anàlisis Clíniques des de l'any 2000.
Oferim activitat docent de pregrau per a Tècnics Especialistes de Laboratori.
Apostem per una formació continuada de qualitat, aspecte fonamental per donar una bona assistència.
Els nostres professionals del Laboratori participen en activitats d'investigació, inclosa la realització de tesis doctorals, publicacions científiques i presentacions a congressos, entre d’altres.
També participen diferents projectes i grups de treball relacionats amb les nostres sots especialitats del laboratori i amb empreses de diagnòstic de l’àrea en el desenvolupament de reactius de laboratori.

El servei està certificat amb la norma UNE-EN-ISO 9001:2015, que garanteix l’excel·lència en tots els processos.
Apliquem controls interns continus i participem en programes externs de qualitat de referència nacional i internacional, assegurant així la fiabilitat i la seguretat dels resultats.
Cada prova és realitzada amb la màxima precisió per professionals altament qualificats, combinant tecnologia avançada i protocols de qualitat estrictes. A continuació, es detallen les principals àrees de coneixement i serveis disponibles: